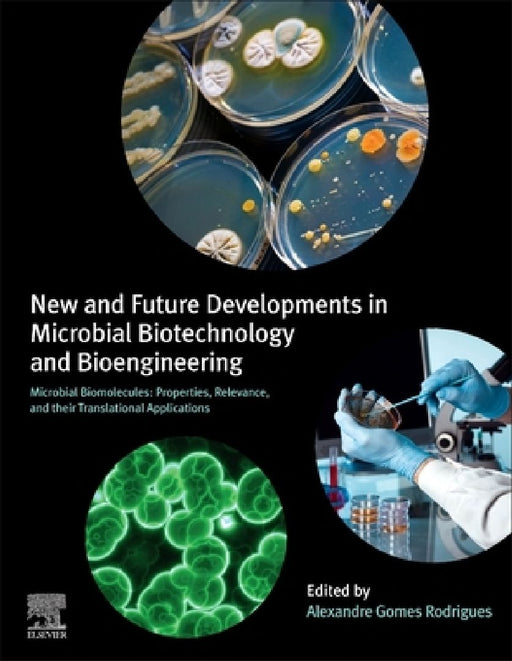
New and Future Developments in Microbial Biotechnology and Bioengineering: Microbial Biomolecules: Properties, Relevance, and Their Translational Applications by Alexandre Gomes Rodrigues

Elsevier
Filters
Removal of Toxic Pollutants through Microbiological and Tertiary Treatment: New Perspectives
Maulin P. Shah
Paperback
• Author(s): Maulin P. Shah • Publisher: Elsevier • Publisher Imprint: Elsevier • BISAC: Chemical & BiochemicalRemoval of Toxic Pollutants through Microbiological and Tertiary Treatment: New Perspectives offers a current account of existing a...
View full detailsReliability Modeling in Industry 4.0
Mangey Ram
Paperback
• Author(s): Mangey Ram • Publisher: Elsevier • Publisher Imprint: Elsevier • BISAC: ManufacturingReliability Modeling with Industry 4.0 explores the emerging theoretical and practical developments in reliability engineering in highly digitized i...
View full detailsRecent Trends and Perspectives on Electrochemical Sensors for Environmental Monitoring
Sibel A. Ozkan
Paperback
• Author(s): Sibel A. Ozkan • Publisher: Elsevier • Publisher Imprint: Elsevier • BISAC: Materials Science - GeneralRecent Trends and Perspectives on Electrochemical Sensors for Environmental Monitoring presents current trends and progress on ele...
View full detailsQuantum Chemistry in the Age of Machine Learning
Pavlo O. Dral
Paperback
• Author(s): Pavlo O. Dral • Publisher: Elsevier • Publisher Imprint: Elsevier • BISAC: Chemistry - Physical & TheoreticalQuantum chemistry is simulating atomistic systems according to the laws of quantum mechanics, and such simulations are e...
View full detailsProperties and Functionalization of Graphene: A Computational Chemistry Approach
Dinadayalane Tandabany
Paperback
• Author(s): Dinadayalane Tandabany • Publisher: Elsevier • Publisher Imprint: Elsevier • BISAC: Chemistry - Physical & TheoreticalProperties and Functionalization of Graphene: Computational Chemistry Approaches, Volume 21 shows how computati...
View full detailsProduction Processes of Renewable Aviation Fuel: Present Technologies and Future Trends
Claudia Gutierrez-Antonio
Paperback
• Author(s): Claudia Gutierrez-Antonio • Publisher: Elsevier • Publisher Imprint: Elsevier • BISAC: Chemical & BiochemicalProduction Processes of Renewable Aviation Fuel: Present Technologies and Future Trends presents the available productio...
View full detailsPorous Coordination Polymers: From Fundamentals to Advanced Applications
Nidhi Goel
Paperback
• Author(s): Nidhi Goel • Publisher: Elsevier • Publisher Imprint: Elsevier • BISAC: Chemistry - Industrial & TechnicalPorous Coordination Polymers: From Fundamentals to Advanced Applications offers a comprehensive coverage the latest advance...
View full detailsPolymer Nanocomposite Membranes for Pervaporation
Sabu Thomas
Paperback
• Author(s): Sabu Thomas • Publisher: Elsevier • Publisher Imprint: Elsevier • BISAC: Materials Science - GeneralPolymer Nanocomposite Membranes for Pervaporation assesses recent applications in the pervaporation performance of polymer nanocompos...
View full detailsPhytonanotechnology: Challenges and Prospects
N. Thajuddin
Paperback
• Author(s): N. Thajuddin • Publisher: Elsevier • Publisher Imprint: Elsevier • BISAC: NanosciencePhytonanotechnology: Challenges and Prospects consolidates information on the use of phytonanoparticles for biomedical, environmental and agricultur...
View full detailsPhytochemistry, the Military and Health: Phytotoxins and Natural Defenses
Andrew G. Mtewa
Paperback
• Author(s): Andrew G. Mtewa • Publisher: Elsevier • Publisher Imprint: Elsevier • BISAC: Life Sciences - BotanyPhytochemistry, the Military and Health: Phytotoxins and Natural Defenses comes as a response to the gap that there has for so long ex...
View full detailsPhotochemistry and Photophysics of Coordination Compounds: Fundamentals and Applications
Rakshit Ameta
Paperback
• Author(s): Rakshit Ameta • Publisher: Elsevier • Publisher Imprint: Elsevier • BISAC: Chemistry - Physical & TheoreticalPhotochemistry and Photophysics of Coordination Compounds: Fundamentals and Applications provides a systematic overview ...
View full detailsPhotocatalytic Systems by Design: Materials, Mechanisms and Applications
Mohan Sakar
Paperback
• Author(s): Mohan Sakar • Publisher: Elsevier • Publisher Imprint: Elsevier • BISAC: Chemical & BiochemicalPhotocatalytic Systems by Design: Materials, Mechanisms and Applications explores various aspects of photocatalysis, including the pho...
View full detailsPetroleum Industry Wastewater: Advanced and Sustainable Treatment Methods
Muftah H. El-Naas
Paperback
• Author(s): Muftah H. El-Naas • Publisher: Elsevier • Publisher Imprint: Elsevier • BISAC: Chemical & BiochemicalPetroleum Industry Wastewater: Advanced and Sustainable Treatment Methods discusses the status of different approaches and advan...
View full detailsOsmosis Engineering
Nidal Hilal
Hardcover
• Author(s): Nidal Hilal • Publisher: Elsevier • Publisher Imprint: Elsevier • BISAC: Chemical & BiochemicalOsmosis Engineering provides a comprehensive overview of the state-of-the-art surrounding osmosis-based research and industrial applic...
View full detailsNovel Nanomaterials for Biomedical, Environmental and Energy Applications
Xiaoru Wang
Paperback
• Author(s): Xiaoru Wang • Publisher: Elsevier • Publisher Imprint: Elsevier • BISAC: BiotechnologyNovel Nanomaterials for Biomedical, Environmental, and Energy Applications is a comprehensive study on the cutting-edge progress in the synthesis a...
View full detailsNew and Future Developments in Microbial Biotechnology and Bioengineering: Recent Advances in Application of Fungi and Fungal Metabolites: Biotechnological Interventions and Futuristic Approaches
Joginder Singh Panwar
Hardcover
• Author(s): Joginder Singh Panwar • Publisher: Elsevier • Publisher Imprint: Elsevier • BISAC: Chemical & BiochemicalNew and Future Developments in Microbial Biotechnology and Bioengineering: Recent Advances in Application of Fungi and Funga...
View full detailsNew and Future Developments in Microbial Biotechnology and Bioengineering: Recent Advances in Application of Fungi and Fungal Metabolites: Current Aspects
Joginder Singh Panwar
Hardcover
• Author(s): Joginder Singh Panwar • Publisher: Elsevier • Publisher Imprint: Elsevier • BISAC: Chemical & BiochemicalNew and Future Developments in Microbial Biotechnology and Bioengineering presents an account of recent developments and app...
View full detailsNickel Base Single Crystals Across Length Scales
Loeïz Nazé
Paperback
• Author(s): Loeïz Nazé • Publisher: Elsevier • Publisher Imprint: Elsevier • BISAC: Materials Science - GeneralNickel Base Single Crystals Across Length Scales is addresses the most advanced knowledge in metallurgy and computational mechanics an...
View full detailsNew and Future Developments in Microbial Biotechnology and Bioengineering: Recent Advances in Application of Fungi and Fungal Metabolites: Environmental and Industrial Aspects
Joginder Singh Panwar
Hardcover
• Author(s): Joginder Singh Panwar • Publisher: Elsevier • Publisher Imprint: Elsevier • BISAC: Chemical & BiochemicalNew and Future Developments in Microbial Biotechnology and Bioengineering: Recent Advances in Application of Fungi and Funga...
View full detailsNew and Future Developments in Microbial Biotechnology and Bioengineering: Recent Advances in Application of Fungi and Fungal Metabolites: Applications in Healthcare
Joginder Singh Panwar
Hardcover
• Author(s): Joginder Singh Panwar • Publisher: Elsevier • Publisher Imprint: Elsevier • BISAC: Chemical & BiochemicalNew and Future Developments in Microbial Biotechnology and Bioengineering: Recent Advances in Application of Fungi and Funga...
View full detailsNanostructures for Novel Therapy: Synthesis, Characterization and Applications
Denisa Ficai
Hardcover
• Author(s): Denisa Ficai • Publisher: Elsevier • Publisher Imprint: Elsevier • BISAC: PharmacologyNanostructures for Novel Therapy: Synthesis, Characterization and Applications focuses on the fabrication and characterization of therapeutic nanos...
View full detailsNew and Future Developments in Microbial Biotechnology and Bioengineering: Microbial Biomolecules: Properties, Relevance, and Their Translational Applications
Alexandre Gomes Rodrigues
Paperback
• Author(s): Alexandre Gomes Rodrigues • Publisher: Elsevier • Publisher Imprint: Elsevier • BISAC: Chemical & BiochemicalNew and Future Developments in Microbial Biotechnology and Bioengineering: Microbial Biomolecules: Properties, Relevance...
View full detailsNanotechnology Safety
Ramazan Asmatulu
Paperback
• Author(s): Ramazan Asmatulu • Publisher: Elsevier • Publisher Imprint: Elsevier • BISAC: Chemical & BiochemicalThe second edition of Nanotechnology Safety outlines the safety, regulatory, and environmental issues related to nanotechnology p...
View full detailsNew and Future Developments in Microbial Biotechnology and Bioengineering: Phytomicrobiome for Sustainable Agriculture
Jay Prakash Verma
Paperback
• Author(s): Jay Prakash Verma • Publisher: Elsevier • Publisher Imprint: Elsevier • BISAC: Chemical & BiochemicalNew and Future Developments in Microbial Biotechnology and Bioengineering: Phytomicrobiome for Sustainable Agriculture provides ...
View full detailsNanotechnology in the Beverage Industry: Fundamentals and Applications
Abdeltif Amrane
Paperback
• Author(s): Abdeltif Amrane • Publisher: Elsevier • Publisher Imprint: Elsevier • BISAC: Materials Science - GeneralNanotechnology in the Beverage industry: Fundamentals and Applications looks at how nanotechnology is being used to enhance water...
View full detailsNanotoxicity: Prevention and Antibacterial Applications of Nanomaterials
Susai Rajendran
Paperback
• Author(s): Susai Rajendran • Publisher: Elsevier • Publisher Imprint: Elsevier • BISAC: NanoscienceNanotoxicity: Prevention, and Antibacterial Applications of Nanomaterials focuses on the fundamental concepts for cytotoxicity and genotoxicity o...
View full detailsNanoscale Processing
Sabu Thomas
Paperback
• Author(s): Sabu Thomas • Publisher: Elsevier • Publisher Imprint: Elsevier • BISAC: NanoscienceNanoscale Processing outlines recent advances in processing techniques for a range of nanomaterial types. New developments in the processing of nanos...
View full detailsNanoscale Graphitic Carbon Nitride: Synthesis and Applications
A. Pandikumar
Paperback
• Author(s): A. Pandikumar • Publisher: Elsevier • Publisher Imprint: Elsevier • BISAC: Materials Science - GeneralNanoscale Graphitic Carbon Nitride focuses on multi-functional applications including energy conversion, storage and healthcare. Po...
View full detailsNanotechnology for the Preparation of Cosmetics using Plant-Based Extracts
Siti Hamidah Mohd Setapar
Paperback
• Author(s): Siti Hamidah Mohd Setapar • Publisher: Elsevier • Publisher Imprint: Elsevier • BISAC: Materials Science - GeneralCosmetic manufacturers use nanoscale size ingredients to provide better UV protection, deeper skin penetration, long-la...
View full detailsNanostructures for Drug Delivery
Ecaterina Andronescu
Hardcover
• Author(s): Ecaterina Andronescu • Publisher: Elsevier • Publisher Imprint: Elsevier • BISAC: PharmacologyNanostructures for Drug Delivery extensively covers the various nanostructured products that have been tested as carriers in target drug de...
View full detailsNanoscale Electrochemistry
Andrew J. Wain
Paperback
• Author(s): Andrew J. Wain • Publisher: Elsevier • Publisher Imprint: Elsevier • BISAC: Materials Science - GeneralNanoscale Electrochemistry focuses on challenges and advances in electrochemical nanoscience at solid-liquid interfaces, highlight...
View full detailsNanomaterials: Synthesis, Characterization, Hazards and Safety
Muhammad Bilal Tahir
Paperback
• Author(s): Muhammad Bilal Tahir • Publisher: Elsevier • Publisher Imprint: Elsevier • BISAC: Materials Science - GeneralNanomaterials: Synthesis, Characterization, Hazards and Safety explains the fundamental properties of nanomaterials, coverin...
View full detailsNano-Optics: Fundamentals, Experimental Methods, and Applications
Sabu Thomas
Paperback
• Author(s): Sabu Thomas • Publisher: Elsevier • Publisher Imprint: Elsevier • BISAC: Materials Science - GeneralNano-Optics: Fundamentals, Experimental Methods, and Applications offers insights into the fundamentals and industrial applications o...
View full detailsNanomaterials Synthesis: Design, Fabrication and Applications
Yasir Beeran Pottathara
Paperback
• Author(s): Yasir Beeran Pottathara • Publisher: Elsevier • Publisher Imprint: Elsevier • BISAC: Materials Science - GeneralNanomaterials Synthesis: Design, Fabrication and Applications combines the present and emerging trends of synthesis route...
View full detailsNanomaterials from Clay Minerals: A New Approach to Green Functional Materials
Aiqin Wang
Paperback
• Author(s): Aiqin Wang • Publisher: Elsevier • Publisher Imprint: Elsevier • BISAC: Materials Science - GeneralNanomaterials from Clay Minerals: A New Approach to Green Functional Materials details the structure, properties and modification of n...
View full detailsNanomedicines for Breast Cancer Theranostics
Nanasaheb D. Thorat
Paperback
• Author(s): Nanasaheb D. Thorat • Publisher: Elsevier • Publisher Imprint: Elsevier • BISAC: NanoscienceNanomedicines for Breast Cancer Theranostics addresses the translational aspects and clinical perspectives of breast cancer nanomedicine from...
View full detailsNanomaterials for Sustainable Energy and Environmental Remediation
Mu Naushad
Paperback
• Author(s): Mu Naushad • Publisher: Elsevier • Publisher Imprint: Elsevier • BISAC: Materials Science - GeneralNanostructured materials, especially, 1D, 2D and 3D nanostructures, and their engineered architectures are being increasingly used due...
View full detailsNanomaterials for the Detection and Removal of Wastewater Pollutants
Barbara Bonelli
Paperback
• Author(s): Barbara Bonelli • Publisher: Elsevier • Publisher Imprint: Elsevier • BISAC: Materials Science - GeneralNanomaterials for the Detection and Removal of Wastewater Pollutants assesses the role of nanotechnology and nanomaterials in imp...
View full detailsNanomaterials for Food Applications
Lopez Rubio Amparo
Paperback
• Author(s): Lopez Rubio Amparo • Publisher: Elsevier • Publisher Imprint: Elsevier • BISAC: Nanotechnology & MEMSNanomaterials for Food Applications highlights recent developments in nanotechnologies, covering the different food areas where ...
View full detailsNanocosmetics: Fundamentals, Applications and Toxicity
Arun Nanda
Paperback
• Author(s): Arun Nanda • Publisher: Elsevier • Publisher Imprint: Elsevier • BISAC: Materials Science - GeneralNanotechnology is key to the design and manufacture of the new generation of cosmetics. Nanotechnology can enhance the performance and...
View full detailsNanomaterials for Electrochemical Energy Storage: Challenges and Opportunities
Rinaldo Raccichini
Paperback
• Author(s): Rinaldo Raccichini • Publisher: Elsevier • Publisher Imprint: Elsevier • BISAC: Materials Science - GeneralNanomaterials for Electrochemical Energy Storage: Challenges and Opportunities, Volume Nineteen provides an objective, realist...
View full detailsNanocarriers for Organ-Specific and Localized Drug Delivery
Muhammad Raza Shah
Paperback
• Author(s): Muhammad Raza Shah • Publisher: Elsevier • Publisher Imprint: Elsevier • BISAC: Materials Science - GeneralOrgan-specific drug delivery is aimed at achieving increased concentration of therapeutic molecules at target sites with minim...
View full detailsNanomaterials for Sensing and Optoelectronic Applications
M. K. Jayaraj
Paperback
• Author(s): M. K. Jayaraj • Publisher: Elsevier • Publisher Imprint: Elsevier • BISAC: Materials Science - GeneralNanomaterials for Sensing and Optoelectronic Applications explores recent trends in nanomaterials and devices for chemical and bios...
View full detailsNanomagnetic Materials: Fabrication, Characterization and Application
Akinobu Yamaguchi
Paperback
• Author(s): Akinobu Yamaguchi • Publisher: Elsevier • Publisher Imprint: Elsevier • BISAC: NanoscienceNanomagnetic Materials: Fabrication, Characterization and Application explores recent studies of conventional nanomagnetic materials in spintro...
View full detailsNanocomposite Membranes for Water and Gas Separation
Mohtada Sadrzadeh
Paperback
• Author(s): Mohtada Sadrzadeh • Publisher: Elsevier • Publisher Imprint: Elsevier • BISAC: Materials Science - GeneralNanocomposite Membranes for Water and Gas Separation presents an introduction to the application of nanocomposite membranes in ...
View full detailsNanomaterials for Air Remediation
Abdeltif Amrane
Paperback
• Author(s): Abdeltif Amrane • Publisher: Elsevier • Publisher Imprint: Elsevier • BISAC: Materials Science - GeneralNanomaterials for Air Remediation provides a comprehensive description of basic knowledge and current research progress in the fi...
View full detailsNanocellulose Based Composites for Electronics
Sabu Thomas
Paperback
• Author(s): Sabu Thomas • Publisher: Elsevier • Publisher Imprint: Elsevier • BISAC: NanoscienceNanocellulose Based Composites for Electronics presents recent developments in the synthesis and applications of nanocellulose composites in electron...
View full detailsNanocarriers for the Delivery of Combination Drugs
Sanjula Baboota
Paperback
• Author(s): Sanjula Baboota • Publisher: Elsevier • Publisher Imprint: Elsevier • BISAC: Materials Science - GeneralNanocarriers for the Delivery of Combination Drugs focuses on the role of nanocarriers in the delivery of combination drugs for t...
View full detailsNanocomposite Membranes for Gas Separation
Pei Sean Goh
Paperback
• Author(s): Pei Sean Goh • Publisher: Elsevier • Publisher Imprint: Elsevier • BISAC: Materials Science - GeneralThe development of a new class of nanocomposite membranes has served as one of the most prominent strategies to address the intrinsi...
View full detailsNanocarriers for Drug Delivery: Nanoscience and Nanotechnology in Drug Delivery
Shyam Mohapatra
Paperback
• Author(s): Shyam Mohapatra • Publisher: Elsevier • Publisher Imprint: Elsevier • BISAC: NanoscienceNano-carriers for Drug Delivery: Nanoscience and Nanotechnology in Drug Delivery presents recent discoveries in research on the pharmaceutical ap...
View full detailsMultifunctional Hybrid Nanomaterials for Sustainable Agri-food and Ecosystems
Kamel A. Abd-Elsalam
Paperback
• Author(s): Kamel A. Abd-Elsalam • Publisher: Elsevier • Publisher Imprint: Elsevier • BISAC: Materials Science - GeneralMultifunctional Hybrid Nanomaterials for Sustainable Agrifood and Ecosystems shows how hybrid nanomaterials (HNMs) are being...
View full detailsNano Tools and Devices for Enhanced Renewable Energy
Sheila Devasahayam
Paperback
• Author(s): Sheila Devasahayam • Publisher: Elsevier • Publisher Imprint: Elsevier • BISAC: Materials Science - GeneralNano Tools and Devices for Enhanced Renewable Energy addresses key challenges faced in major energy sectors as the world striv...
View full detailsMultiscale Modeling Approaches for Composites
George Chatzigeorgiou
Paperback
• Author(s): George Chatzigeorgiou • Publisher: Elsevier • Publisher Imprint: Elsevier • BISAC: MechanicalMultiscale Modeling Approaches for Composites outlines the fundamentals of common multiscale modeling techniques and provides detailed guida...
View full detailsMultifunctional Nanocarriers
Neelesh Kumar Mehra
Paperback
• Author(s): Neelesh Kumar Mehra • Publisher: Elsevier • Publisher Imprint: Elsevier • BISAC: Materials Science - GeneralMultifunctional Nanocarriers provides information on the concept, theory and application of multifunctional nanocarriers. The...
View full detailsMotion and Path Planning for Additive Manufacturing
Alex C. Roschli
Paperback
• Author(s): Alex C. Roschli • Publisher: Elsevier • Publisher Imprint: Elsevier • BISAC: MechanicalMotion and Path Planning for Additive Manufacturing takes a deep dive into the concepts and computations behind slicing software - the software th...
View full detailsMolecular Modeling of the Sensitivities of Energetic Materials
Didier Mathieu
Paperback
• Author(s): Didier Mathieu • Publisher: Elsevier • Publisher Imprint: Elsevier • BISAC: Chemistry - Physical & TheoreticalMolecular Modeling of the Sensitivities of Energetic Materials, Volume 22 introduces experimental aspects, explores the...
View full detailsMicrofluidic Cell Culture Systems
Jeffrey T. Borenstein
Paperback
• Author(s): Jeffrey T. Borenstein • Publisher: Elsevier • Publisher Imprint: Elsevier • BISAC: NanoscienceTechniques for microfabricating intricate microfluidic structures that mimic the microenvironment of tissues and organs, combined with the ...
View full detailsMicrofluidics for Cellular Applications
Gerardo Perozziello
Paperback
• Author(s): Gerardo Perozziello • Publisher: Elsevier • Publisher Imprint: Elsevier • BISAC: Materials Science - GeneralMicrofluidics for Cellular Applications describes microfluidic devices for cell screening from a physical, technological and ...
View full detailsMicro and Nanofluid Convection with Magnetic Field Effects for Heat and Mass Transfer Applications using MATLAB®
Chakravarthula S. K. Raju
Paperback
• Author(s): Chakravarthula S. K. Raju • Publisher: Elsevier • Publisher Imprint: Elsevier • BISAC: Materials Science - GeneralMicro and Nanofluid Convection with Magnetic Field Effects for Heat and Mass Transfer Applications using MATLAB(R) exam...
View full detailsMicro- and Nano-Bionic Surfaces: Biomimetics, Interface Energy Field Effects, and Applications
Deyuan Zhang
Paperback
• Author(s): Deyuan Zhang • Publisher: Elsevier • Publisher Imprint: Elsevier • BISAC: MechanicalMicro- and Nano-Bionic Surfaces: Biomimetics, Interface Energy Field Effects, and Applications synthesizes the latest research in bio-inspired surfac...
View full details